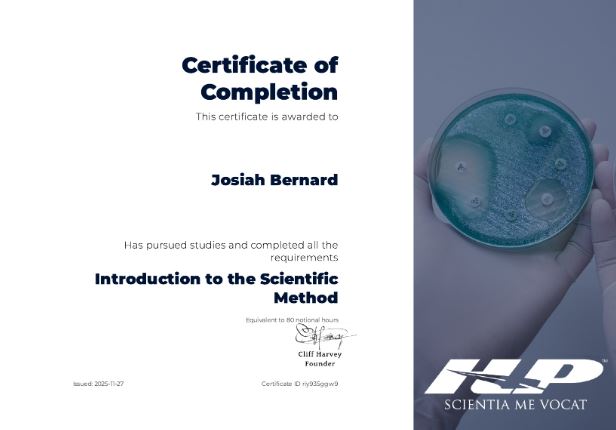

Kia ora, I’m Josiah Bernard, a Functional Diagnostic Nutritionist, Certified Nutrition Coach and Health Coach, as well as a Clinical Nutritionist in Training; based in Waikato, New Zealand.
I work with both men and women across all areas of nutrition and health, from body composition and sports performance, to metabolic health, mental wellbeing, and longevity.
My approach to nutrition is integrative, evidence-based, and personal. I don’t believe in ‘one size fits all’ programmes or quick fixes. I believe in understanding your unique biology, your lifestyle, and your goals and building a strategy that truly fits your life.

With over 8 years worth of personal experience in health, fitness, and thousands of hours learning nutrition science from New Zealand renown experts and globally recognized professionals; I am stoked to help you achieve your Hauora goals.
My interest in nutrition wasn’t born in a classroom, it started with my own 10-year journey of health and wellness. After years of battling my own health issues, working with professionals and researching and experiencing firsthand the profound impact that food and lifestyle has on how we think, feel, and function, I became compelled to formalise that knowledge, branch out, delve deep and use my skillset to help others with their health challenges.
I’ve studied under New Zealand-renowned experts and globally recognised professionals in the fields of nutrition science, functional medicine, sports performance, health coaching, and clinical nutrition. I continue to invest in ongoing education because this field and the science moves fast l and my clients deserve the most current, evidence-based support available.

On a mission to help you reach your Health, Performance and Body Composition goals.
Located in:
Waikato, New Zealand
